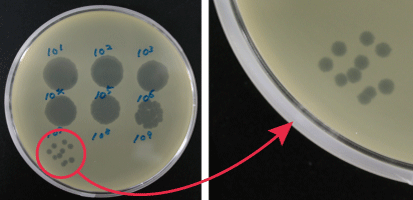
培養下での光学顕微鏡像

NBRCニュース 第32号
◆◇◆ ━━━━━━━━━━━━━━━━━━━━━━━━━━━ ◆◇◆
NBRCニュース No. 32(2015.3.31)
◆◇◆ ━━━━━━━━━━━━━━━━━━━━━━━━━━━ ◆◇◆
NBRCニュース第32号をお届けします。今号は微生物あれこれ、微生物の培養
法の2つの連載をお届けします。最後までお読みいただければ幸いです。
======================================================================
内容
======================================================================
1.NITE講座「バイオテクノロジーのためのリスクガバナンス」受講生募集
のお知らせ
2.新たにご利用可能となった微生物株
3.微生物あれこれ(29)
油脂を生産する海洋性真核微生物:ラビリンチュラ類
4.微生物の培養法(16)
バクテリオファージの簡易調製法と力価確認法
======================================================================
1.NITE講座「バイオテクノロジーのためのリスクガバナンス」受講生募集
のお知らせ
======================================================================
微生物の利用における微生物そのものの安全性、遺伝子組換え体の安全性の
確保、生物多様性条約の発効にともなう海外微生物の取扱い等、微生物に関す
る安全性や規制に関して考察するとともに、微生物の保存、提供に伴う品質管
理の最新技術や微生物の活用例についての講座を開講します。参加費は無料で
す。皆様のご参加をお待ちしております。
日時:2015年4月16日(木)~7月30日(木)の毎木曜日(全15回)
18:30~20:30
場所:独立行政法人製品評価技術基盤機構
東京都渋谷区西原2-49-10
https://www.nite.go.jp/nite/aboutus/jigyosho/nite_map.html
京王新線幡ヶ谷駅から徒歩約10分
小田急線・東京メトロ千代田線代々木上原駅から徒歩約15分
講義名:(1) 安全性とリスクの考え方
(2) 微生物を使用した実験に関する注意事項
(3) 病原微生物のゲノム解析
(4) 微生物のゲノムアノテーションとその利用
(5) 微生物の分類と安全性評価
(6) バイオと製品安全
(7) 微生物を用いた環境修復手法と安全性
(8) 遺伝子組換え体の利用
(9) 知的基盤と利用促進
(10) 微生物の保存と品質管理
(11) 海外の微生物の入手と持ち出し
(12) 特殊環境微生物
(13) 藻類によるバイオエネルギー生産
(14) 特許微生物について
(15) 今後の微生物の利用のあり方
お申込み方法や詳細な内容につきましては、以下のウェブページをご覧くだ
さい。
【詳細】 https://www.nite.go.jp/nbrc/information/2015_bio-kouza.html
その他、NITEでは「製品安全のためのリスクガバナンス」と「化学物質のた
めのリスクガバナンス(募集終了)」の2つの講座も開催しております。
【その他の講座】
https://www.nite.go.jp/jiko/event/kouza/2015fy/index2015.html
https://www.nite.go.jp/chem/news/info20150302.html
======================================================================
2.新たにご利用可能となった微生物株
======================================================================
◆ NBRC株、ゲノムDNA
酵母 8株、糸状菌 3株、細菌 31株、アーキア 4株、バクテリオファージ 1
株、微生物ゲノムDNA 2種類が、新たにご利用可能となりました。
【詳細】
https://www.nite.go.jp/nbrc/cultures/nbrc/new_strain/new_dna.html
◆ RD株
モンゴルとミャンマーの発酵食品由来の酵母と乳酸菌などが、新たにご利用
可能となりました。また、RD株リストのページを新しくして、国内産とミャン
マー産の菌株リストを公開し、分離源ごとの菌株数もまとめましたのでご覧く
ださい。新規リストの公開に伴い、リストのみをまとめたページも公開してお
ります。菌株選定のご参考になさってください。
【詳細】 https://www.nite.go.jp/nbrc/cultures/rd/new_rd.html
【RD株リスト】
https://www.nite.go.jp/nbrc/cultures/rd/available_rd_list.html
======================================================================
3.微生物あれこれ(29)
油脂を生産する海洋性真核微生物:ラビリンチュラ類 (関本訓士)
======================================================================
ラビリンチュラ類はクロミスタ界(もしくはより近年の考え方として不等毛
界:遊泳細胞の前鞭毛表面に基部・軸部・先端部の三部から構成される管状小
毛(マスチゴネマ)を持つことで特徴付けられる系統群 (1))に属する真核微
生物で、海洋に普遍的に生息しています。1990年代中頃より油脂、特に高度不
飽和脂肪酸を細胞内に多く蓄積する産業上有用な微生物として知られてきまし
た。本生物の特徴および培養法はNBRCニュース第18号でご紹介しましたが、今
回はラビリンチュラ類が生産する油脂の産業利用、およびNBRCが現在行ってい
る事業について簡単にご紹介いたします。
図1:
不等毛界に属する生物の遊泳細胞の模式図
遊泳細胞の前鞭毛表面には管状小毛(マ
スチゴネマとも呼ぶ)と呼ばれる構造があ
り、この小毛は基部、軸部、先端毛の三構
造から構成されています(先端毛の数や軸
部の構造には不等毛界の中で多様性が見ら
れます)。マスチゴネマは他のいくつかの
真核生物系統群においても見られますが、
マスチゴネマが管状の三部構成であるとい
う形態形質は真核生物内において不等毛界
にしか見られず、この界を特徴付ける形質
として認識されています。
図2:
不等毛界に属する卵菌類Haliphthoros sp.
の透過型電子顕微鏡ホールマウント像
(Bar 1 µm)
前鞭毛表面にマスチゴネマを観察するこ
とができます。
◆ 高度不飽和脂肪酸
ラビリンチュラ類はドコサヘキサエン酸(DHA)やドコサペンタエン酸
(DPA)といった高度不飽和脂肪酸を細胞内に多く蓄積することが特徴で、中
にはDHA含有量が細胞内全脂肪酸の80%以上に達する菌もいます (2, 3)。ご存
じの通り、DHAには抗血栓、抗炎症作用があり、粉ミルクや多くの機能性食品
に添加されています (4)。これらの食品に含まれるDHAの多くは魚油由来です
が、ラビリンチュラ類から抽出されたDHAを添加した栄養補助食品が海外では
既に販売されています。前述したように高度不飽和脂肪酸にはDHAやDPAなどい
くつかの種類がありますが、それらの細胞内における存在割合は属間で異なっ
ており、この違いは属の分類形質の一つとしても利用されています。例えば、
Aurantiochytrium属はDHAのみを多く含むのに対し、Schizochytrium属はDHAと
アラキドン酸、Oblongichytrium属はDHAとDPAを多く含みます (3)。目的の高
度不飽和脂肪酸を多く生産する属の菌株を探索することで、その脂肪酸の大量
生産を行える可能性がありますが、いまだ脂肪酸組成が調べられていないラビ
リンチュラのグループも多く存在しています。
◆ 炭化水素
Aurantiochytrium属はスクワレン(squalene)という炭化水素を細胞内に多
く蓄積します。このスクワレンは、深海鮫の肝油から作られるサプリメントと
して知られており、化粧品の保湿剤としても利用されています。深海鮫の代わ
りとなる安定的な供給源として、ラビリンチュラ類が期待されています。さら
に、スクワレンは原油に近い成分のためバイオディーゼルとしての利用も検討
されています (5)。
◆ ラビリンチュラ類に対するNBRCの取り組み
NBRCではこれまでも多様なラビリンチュラ類の菌株を保存してきましたが、
昨年からはより精力的に新規菌株の分離、培養、同定、保存に取り組んできて
おります。昨年7月はモンゴル、今年1月はベトナムに渡航し、現地にて約250
株の新規ラビリンチュラ類菌株を分離し、NBRCへ移転しました。海のないモン
ゴルのどこにラビリンチュラ類が?と思われるかもしれませんが、モンゴルに
多く存在する塩湖(陸に閉ざされた塩水をたたえた湖)から多くのラビリンチ
ュラ類が分離されました。これらの新規ラビリンチュラ類菌株はRD株として皆
様にご提供してまいります。また、長期保存法の改良、分子同定法の開発、脂
肪酸組成解析なども行っており、これらの菌株や技術がラビリンチュラをお使
いの企業、大学の皆様のお役にたてばと考えております。
【文献】
(1) Anderson, Cavalier-Smith (2012). Acta Protozool. 51, 291-304.
(2) 横地, 中原 (2001). 海洋と生物 23, 39-44.
(3) Yokoyama, Honda (2007). Mycoscience 48, 199-211.
(4) 中原 (1995). 油化学44, 821-827.
(5) 彼谷 (2011), 養殖 48, 29-32.

図3:ラビリンチュラ類2科の細胞模式図(Porter (1990) in “Handbook of
Protoctista”を改変)。
左:ラビリンチュラ科 (Labyrinthulaceae)
右:ヤブレツボカビ科 (Thraustochytriaceae)
ラビリンチュラ類はボスロソーム (bothrosome:赤丸)と外質ネット (Ecto-
plasmic network:青矢印)という二つの形態形質で特徴付けられます。

図4:培養下での光学顕微鏡像(Bar 50 µm)。矢印:外質ネット。
左:Labyrinthula sp. NBRC 33215(ラビリンチュラ科)
右:Oblongichytrium sp. NBRC 102618(ヤブレツボカビ科)
======================================================================
4.微生物の培養法(16)
バクテリオファージの簡易調製法と力価確認法 (藤田克利)
======================================================================
NBRCニュースNo.8「微生物培養法(4)バクテリオファージ」でご紹介
した復元培養法では、ファージを生育させたトップアガーをかき集めてファー
ジを回収しますが、使用する平板培地の枚数が多い場合、この方法は煩雑にな
りがちです。今回は簡易なファージ溶液の調製方法と力価の確認方法をご紹介
します。
◆ 簡易調製法の手順
(1) 「微生物培養法(4)バクテリオファージ」の「復元培養」の手順(1)~
(4)にしたがって、ファージを復元・培養します。
(2) 宿主菌の培養に用いる液体培地4 mLを平板培地上に重層し、4℃で8時間か
ら一晩静置します。
(3) 重層した液体培地をシリンジで回収し、孔径0.2 µmのフィルターをつけて
濾過滅菌します。濾過液にファージが含まれています。ファージ懸濁液、
液体培地がアガーに吸収されることや濾過時のロスにより、3 mL程度に減
ります。また、重層した液体培地に宿主菌が多く混在している場合は、フ
ィルターが詰まる可能性があるため、一度遠心操作で宿主菌を分離した方
がよいでしょう。
簡易法では、トップアガーから培地に拡散・移動してきたファージを回収し
ています。トップアガー内にファージがある程度残りますので、より高い力価
のファージ懸濁液を調製したい場合は「微生物培養法(4)バクテリオファー
ジ」のトップアガーを回収する方法を用いるか、重層する液体培地の量を減ら
してください。
次にお問い合わせの多い、ファージの力価の確認法をご紹介します。
◆ 力価確認法の手順
(1) 「微生物培養法(4)バクテリオファージ」の「培地の調製」(1)~(4)に
したがって、宿主菌をトップアガーで包埋したシャーレを用意します。
(2) ファージ懸濁液を液体培地で10の12乗程度まで段階希釈し(10の1乗から
12乗の12段階の希釈液を用意)、(1)のシャーレに各希釈液を10 µL滴下し
ます。希釈液は後ほど使用するので、冷蔵保存します。
(3) 乾燥後、インキュベーターで培養してください。滴下した部分にファージ
が増殖してできたプラークを数えます。10の12乗希釈した懸濁液でプラー
クが多すぎて数えられない場合は、更に希釈して再度実験してください。
正確な数を求めるために、さらに以下の実験を行います。
(4) (3)で測定したプラーク数が10の10乗希釈で100~200個程度、11乗で数10
個程度、12乗で数個であったファージ懸濁液の場合、(2)で冷蔵保存した
10乗と11乗の2種類の希釈液を用いて実験を行います。12乗は誤差が大き
いと思われるため、使用しません。選んだ2種類の段階の希釈液10 µLを宿
主菌液0.1 mLと混合し、培養温度で15分静置します。
(5) (4)を42~45℃で保温したトップアガー4 mLと混合し、同じく保温したボ
トムプレートに広げます。アガーが固化したらインキュベーターに移し培
養します。プラークの数が多く、プラークがつながるおそれがある場合は
(4)で加えるファージ懸濁液を5 µLにしてください。
(6) 2段階の懸濁液それぞれから得られたプラークを数え、その平均から力価
を計算します。例えば、10の10乗希釈で156個、11乗で21個の場合の力価
は以下となります。
力価:(156+21×10)/2×10の10乗 = 1.8×10の12乗

段階希釈を用いたプラーク形成数の計測による力価確認
======================================================================
編集後記
======================================================================
NBRC発ラビリンチュラクッキーを作りたくなりました。栄養補助と美容によ
いクッキーです。私は健康だけが取り柄で、お肌は昔から年の割にきれいだと
言われますので、CMガールも努めます。大ヒットして10年後にはL-乾燥アンプ
ルを作製する実験室がクッキーの製造ラインになっているかもしれません。
・・・と妄想してみましたが、二番煎じのアイディアでは借金を作って終わ
るだけですね。CMガールが若くないというクレームもきそうです。(KY)
◆◇◆ ━━━━━━━━━━━━━━━━━━━━━━━━━━━ ◆◇◆
・画像付きのバックナンバーを以下のサイトに掲載しております。受信アドレ
ス変更、受信停止も以下のサイトからお手続きいただけます。
https://www.nite.go.jp/nbrc/cultures/others/nbrcnews/nbrcnews.html
・NBRCニュースは配信登録いただいたメールアドレスにお送りしております。
万が一間違えて配信されておりましたら、お手数ですが、下記のアドレスに
ご連絡ください。
・ご質問、転載のご要望など、NBRCニュースについてのお問い合わせは、下記
のアドレスにご連絡ください。
・掲載内容は予告なく変更することがございます。掲載内容を許可なく複製・
転載されることを禁止します。
・偶数月の1日(休日の場合はその前後)に配信します。第33号は6月1日に配
信予定です。
編集・発行
独立行政法人製品評価技術基盤機構(NITE)バイオテクノロジーセンター
NBRCニュース編集局(nbrcnews@nite.go.jp)
◆◇◆ ━━━━━━━━━━━━━━━━━━━━━━━━━━━ ◆◇◆
お問い合わせ
-
独立行政法人製品評価技術基盤機構 バイオテクノロジーセンター
生物資源利用促進課
(お問い合わせはできる限りお問い合わせフォームにてお願いします)
-
TEL:0438-20-5763
住所:〒292-0818 千葉県木更津市かずさ鎌足2-5-8 地図
お問い合わせフォームへ